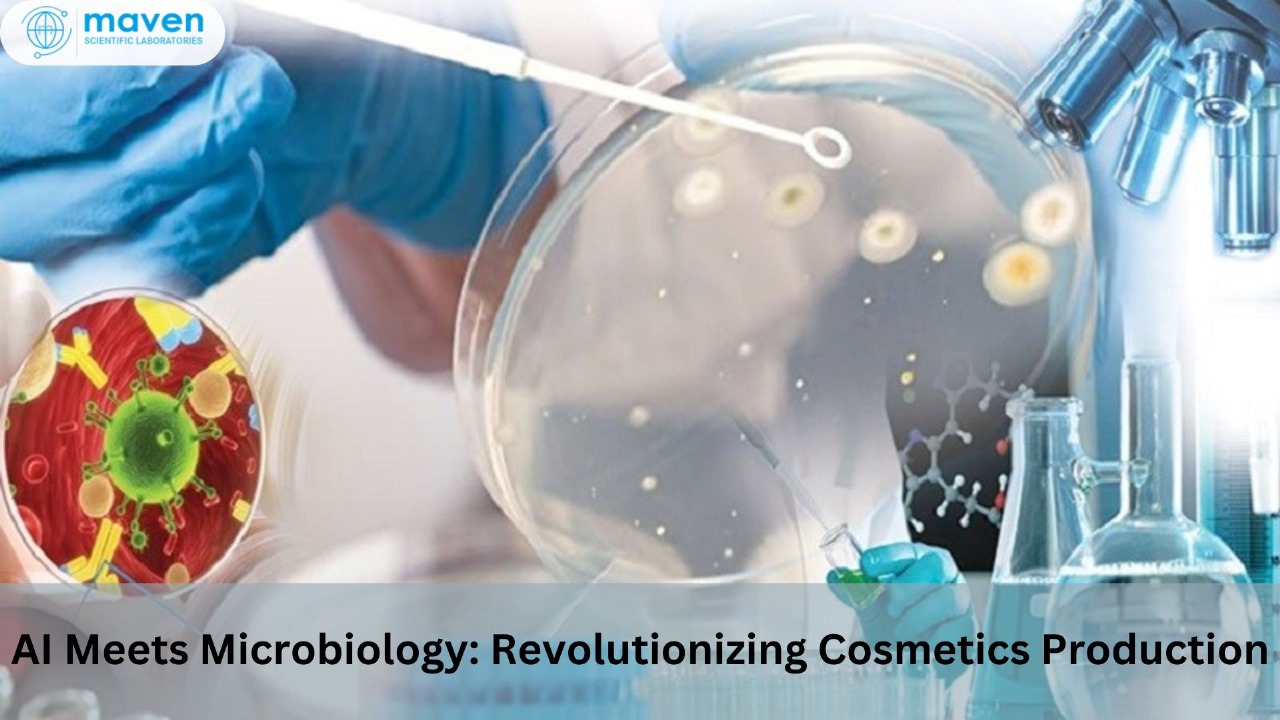

December 17, 2024
The cosmetics industry is entering a new era driven by technological innovation, where artificial intelligence is transforming traditional scientific disciplines. One of the most impactful integrations is the application of AI within microbiological monitoring and quality control processes in cosmetic manufacturing.
By combining advanced data analytics with microbiological testing systems, artificial intelligence enables manufacturers to detect contamination risks earlier, optimize formulation development, and enhance production efficiency.
AI-powered systems are now being used to improve microbial detection, contamination risk prediction, automated quality monitoring, and sustainable formulation development, making them essential tools in modern cosmetic manufacturing.
For organizations operating in regulated global markets, integrating advanced digital technologies into microbiological quality systems also supports compliance with regulatory frameworks such as the ISO 22716 Cosmetics Good Manufacturing Practices and the EU Cosmetics Regulation (EC) No 1223/2009.
Maven Regulatory Solutions supports cosmetic manufacturers in navigating these evolving technological and regulatory landscapes by providing regulatory consulting, quality system support, microbiological risk assessment, and product safety documentation services.
The Role of Microbiology in Cosmetic Manufacturing
Microbiological quality control is a critical component of cosmetic product safety. Cosmetic products, especially water-based formulations such as creams, lotions, and serums, can become susceptible to microbial contamination if not properly monitored.
Microbial contamination can lead to:
- Product spoilage
- Reduced product shelf life
- Consumer health risks
- Product recalls and regulatory action
Cosmetic manufacturers must therefore maintain strict microbiological testing protocols throughout the product lifecycle.
Common Microbial Contaminants in Cosmetics
| Microorganism | Risk to Product | Potential Impact |
| Pseudomonas aeruginosa | Water-based product contamination | Skin infections |
| Staphylococcus aureus | Poor sanitation contamination | Skin irritation |
| Candida albicans | Fungal growth in creams | Product degradation |
| Escherichia coli | Manufacturing contamination | Regulatory non-compliance |
AI technologies are now improving how these microbial risks are detected and controlled.
AI-Driven Microbial Detection and Environmental Monitoring
One of the most promising applications of artificial intelligence in cosmetics manufacturing is real-time contamination detection.
AI-powered vision systems and machine learning algorithms can continuously analyze environmental monitoring data from production facilities.
Benefits of AI-Based Microbial Monitoring
| Capability | Traditional Method | AI-Driven Method |
| Inspection frequency | Periodic manual testing | Continuous monitoring |
| Data analysis | Human interpretation | Automated predictive analytics |
| Contamination detection speed | Hours or days | Real-time detection |
| Risk prediction | Reactive | Predictive |
By identifying microbial contamination risks earlier in the production process, AI systems help prevent large-scale product failures.
Intelligent Quality Control Systems
Artificial intelligence enables a new generation of automated quality control systems that combine microbiological data with production analytics.
These systems integrate information from:
- environmental sensors
- microbial test results
- production equipment data
- ingredient traceability systems
AI algorithms can then identify patterns associated with contamination risks or quality deviations.
Key Advantages of AI-Powered Quality Control
| Advantage | Operational Impact |
| Real-time quality monitoring | Faster corrective actions |
| Automated deviation detection | Reduced production losses |
| Predictive risk assessment | Preventing contamination events |
| Data-driven decision making | Improved manufacturing efficiency |
These technologies support compliance with cosmetic quality standards and Good Manufacturing Practices.
AI-Powered Predictive Modeling for Cosmetic Formulation
Traditional cosmetic formulation relies heavily on experimental trials and laboratory testing. While effective, this process can be time-consuming and resource intensive.
Artificial intelligence is transforming this process through predictive formulation modeling.
AI models analyze large datasets containing:
- ingredient properties
- formulation stability data
- toxicity and safety profiles
- consumer performance feedback
Using this information, predictive algorithms can estimate the outcome of new formulations before physical prototypes are created.
AI Benefits in Cosmetic Formulation Development
| Process Stage | Traditional Approach | AI-Enhanced Approach |
| Ingredient selection | Trial and error | Data-driven selection |
| Formulation stability | Long testing cycles | Predictive modeling |
| Development timelines | Several months | Accelerated development |
| Material waste | Higher waste | Reduced waste |
This approach allows cosmetic brands to accelerate innovation while maintaining product safety and regulatory compliance.
Sustainability and Resource Optimization
The cosmetics industry is increasingly focused on sustainability and environmentally responsible manufacturing practices.
AI technologies contribute to sustainability goals by optimizing ingredient usage and minimizing waste during formulation development.
Sustainability Benefits of AI in Cosmetic Production
| Sustainability Factor | Impact |
| Reduced formulation trials | Lower material waste |
| Efficient ingredient use | Reduced environmental footprint |
| Optimized manufacturing processes | Lower energy consumption |
| Improved product stability | Reduced product disposal |
These innovations support companies seeking to meet environmental responsibility and sustainability targets.
Human Expertise and Artificial Intelligence Collaboration
Despite its powerful analytical capabilities, artificial intelligence does not replace scientific expertise. Instead, AI acts as a decision-support tool that enhances the capabilities of microbiologists, formulation scientists, and quality assurance professionals.
By automating routine tasks such as data analysis and microbial monitoring, AI allows experts to focus on:
- complex product development strategies
- safety evaluations
- regulatory compliance
- innovation in cosmetic formulations
This collaboration between human expertise and digital intelligence creates a more resilient and adaptive quality system.
Regulatory Considerations for AI in Cosmetic Manufacturing
As AI technologies become integrated into cosmetic production systems, regulatory compliance remains essential.
Manufacturers must ensure that AI-driven processes align with global regulatory standards.
Key Regulatory Considerations
| Regulatory Area | Importance |
| Microbiological testing standards | Ensure product safety |
| Cosmetic GMP compliance | Maintains manufacturing quality |
| Ingredient safety assessment | Preventing toxicological risks |
| Product safety documentation | Supports regulatory approval |
These requirements are essential to maintain product safety and ensure compliance with international cosmetics regulations.
Emerging Trends in AI-Driven Cosmetic Manufacturing
The adoption of artificial intelligence in cosmetics manufacturing is accelerating rapidly.
Key Industry Trends
| Trend | Industry Impact |
| AI-enabled microbiology laboratories | Faster contamination detection |
| Automated manufacturing quality control | Reduced human error |
| Digital twin technology in formulation | Simulation-based product design |
| AI-driven ingredient safety analytics | Enhanced toxicological assessment |
Companies that adopt these technologies early gain a significant competitive advantage in innovation and efficiency.
The Role of Maven Regulatory Solutions
As artificial intelligence continues to transform cosmetic manufacturing, companies must ensure that these technological advancements align with regulatory requirements.
Maven Regulatory Solutions provides specialized regulatory consulting services to support cosmetics companies integrating advanced technologies into their manufacturing systems.
Maven Regulatory Expertise
| Service Area | Support Provided |
| Cosmetic regulatory strategy | Global compliance guidance |
| Product safety documentation | CPSR and safety reports |
| Microbiological risk assessment | Manufacturing safety evaluation |
| GMP compliance consulting | Quality system implementation |
| Regulatory intelligence monitoring | Ongoing compliance updates |
By combining regulatory expertise with industry insights, Maven helps cosmetics manufacturers maintain compliance while adopting innovative technologies.
Conclusion
Artificial intelligence is reshaping the cosmetics industry by transforming microbiological monitoring, quality assurance systems, and formulation development processes. The integration of AI technologies into cosmetic manufacturing enables faster contamination detection, predictive formulation modeling, and improved sustainability.
These advancements not only enhance product quality and operational efficiency but also support compliance with global cosmetic regulatory standards.
As the industry continues to evolve, companies that successfully integrate artificial intelligence into their microbiological and quality control systems will be better positioned to meet growing consumer expectations for safety, innovation, and sustainability.
With expert regulatory guidance from Maven Regulatory Solutions, cosmetics manufacturers can confidently adopt emerging technologies while ensuring regulatory compliance and maintaining the highest standards of product safety.
Frequently Asked Questions (FAQs)
1. How is artificial intelligence used in cosmetic microbiology?
AI is used to analyze microbial testing data, detect contamination risks, monitor production environments, and improve microbiological quality control processes.
2. Why is microbiological testing important for cosmetic products?
Microbiological testing ensures that cosmetic products are free from harmful microorganisms that could compromise product safety or cause consumer health risks.
3. Can AI improve cosmetic formulation development?
Yes. AI-based predictive modeling can analyze ingredient interactions and forecast formulation outcomes, significantly reducing development time and material waste.
4. What regulatory standards apply to microbiological safety in cosmetics?
Cosmetic manufacturers must follow standards such as ISO 22716 Cosmetics Good Manufacturing Practices and comply with global cosmetics regulations governing product safety and manufacturing quality.
5. How can Maven Regulatory Solutions support cosmetic manufacturers?
Maven Regulatory Solutions provides regulatory consulting, microbiological risk assessment, GMP compliance support, product safety documentation preparation, and global cosmetics regulatory strategy services.

Post a comment